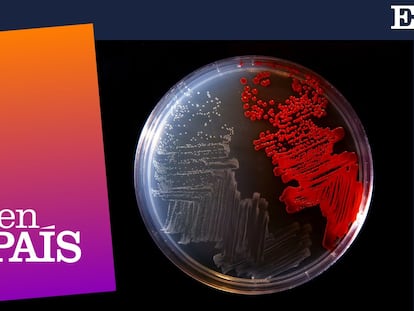

Las patatas podridas esconden un potente fármaco contra hongos, incluidos los humanos
Investigadores españoles y británicos descubren que una bacteria patógena para este cultivo produce un fungicida de amplio espectro

Investigadores españoles y británicos descubren que una bacteria patógena para este cultivo produce un fungicida de amplio espectro
La microbióloga María del Mar Tomás, que lleva 15 años investigando los mecanismos de las resistencias antimicrobianas, apuesta por usar virus bacteriófagos para neutralizar a las superbacterias

Aunque el antibiótico acabe con la infección, no elimina los daños que esta ha ocasionado si llega a una fase avanzada
El mal uso de los antibióticos en el último medio siglo ha provocado que algunos microorganismos se hayan hecho resistentes a ellos. Los científicos estiman que en 2030 pueden matar más que el cáncer

Un equipo de EE UU relata el primer caso de una persona que supera las heridas causadas por ‘M. chelonae’ con un tratamiento experimental en auge

La ciencia no para. Busca, fracasa, persevera, encuentra, revisa, mejora, perfecciona. Y vuelta a empezar. Estos son algunos de los avances médicos que vienen.

Tras dos años de la pandemia, la comunidad internacional tiene poco interés en abordar el problema de los patógenos resistentes a los medicamentos. Pero destacar los vínculos de este fenómeno con el calentamiento global y los conflictos podría alentar a los líderes mundiales a reconsiderar sus prioridades

El ECDC lanza una alerta por el auge de la bacteria shigella sonnei en varios países entre hombres que tienen sexo con otros hombres. El bacilo, que ya ha mostrado resistencias a antibióticos, provoca problemas intestinales

Un equipo de científicos españoles desarrolla una técnica para hallar nuevos genes asociados a la resistencia a uno de los dos antibióticos principales contra la tuberculosis: la isoniazida, y así poder buscar nuevas formas de tratarla

El mayor estudio de la historia, un análisis del agua de 258 ríos del mundo, alerta de “una amenaza global para el medio ambiente y para la salud humana”

Dani Río es uno de los miles de pacientes que sufren infecciones resistentes a antibióticos cada año en España, un problema que mata cuatro veces más que los accidentes de tráfico

En 30 años se habrán multiplicado por 10 las muertes causadas por infecciones ante las que los antibióticos son ineficaces

Samuel Ponce de León, experto de la UNAM en prevención y control de infecciones, da consejos prácticos para la cuarta ola de contagios en México: desde las pruebas hasta el tratamiento de síntomas

El mayor estudio hasta la fecha alerta de que cada año fallecen 1,2 millones de personas por infecciones resistentes a antibióticos, un número que se multiplicará por 10 en 2050

Científicos y médicos describen cómo salvaron a una ciudadana belga herida en un atentado de una bacteria resistente a todos los antibióticos

Los lectores escriben sobre los antibióticos, las vacunas, los trabajos precarios y la añoranza de España de quienes viven en otro país
Las autoridades alertan de que los antibióticos están dejando de funcionar y de que la humanidad se dirige a un futuro en el que cualquier herida podría ser letal

El hallazgo, liderado por el español César de la Fuente, permite localizar fragmentos biológicos de proteínas con funciones antiinfecciosas en todo el cuerpo

Vaxdyn supera las fases preclínicas de su formulación contra las bacterias resistentes a los antibióticos y espera empezar los ensayos con humanos en dos años

Ainoa Nieto es la veterinaria que dirige en las Islas Galápagos las investigaciones sobre las tortugas gigantes en la fundación que lleva el nombre del padre de la teoría de la evolución

Los científicos están recurriendo a los depredadores naturales de las bacterias para tratar las infecciones, en un problema que se ha convertido en unos de los grandes desafíos de la medicina moderna

Noma y pian son dos dolencias desatendidas que afectan especialmente a menores de edad. Sus cicatrices estigmatizan de por vida. Un hospital que las opera en Nigeria y algunos avances científicos en la forma de administrar un antibiótico, ayudan a paliar y curar sus efectos

La científica Edith Heard dirige el Laboratorio Europeo de Biología Molecular, con 1.800 trabajadores dedicados a revelar los secretos de la vida
La covid-19 de este siglo y la enfermedad bacteriana de la que escribió Dickens en el siglo XIX comparten su impacto social y las consecuencias de la desinformación. Así lo muestran sus cartas recién descubiertas y publicadas como parte de Dickensletters.com

Causa cada año más muertes de menores de cinco años en el mundo que cualquier otra enfermedad: más de 800.000. En la mayoría de los casos se podrían haber evitado, puesto que resulta fácil detectarla, es prevenible y curable. Pero algo falla

Nuevas vacunas y pruebas simples, fiables y asequibles centran los esfuerzos globales de investigación contra esta enfermedad asesina impenitente que causa más de 2.000 muertes al día
Con un 19% de vidas infantiles perdidas por esta enfermedad prevenible y curable, es el país más afectado del mundo. Gobierno e iniciativas internacionales buscan reducir la cifra con un nuevo plan. La pandemia es un freno, pero también un acicate

El nuevo medicamento, liderado por un científico español, logra que el 80% de los ratones en los que se probó sobreviva a una infección letal

De algunas cosas sabemos más que la media, pero de otras vamos rezagados: respuestas para borrar el “necesita mejorar”

Un grupo de investigadores obtiene la secuencia genética de la cepa original de Penicillium, un hallazgo que también puede ayudar a combatir las resistencias actuales

El mal uso de los antibióticos reduce su eficacia y para las empresas farmacéuticas no es rentable la creación de nuevos medicamentos que los sustituyan
Sanidad elabora una lista de fármacos esenciales para asegurar sus existencias durante la epidemia

La organización calcula que los servicios de rehabilitación han sido los más afectados por la crisis sanitaria

Un estudio demuestra en Andalucía que los fármacos recuperan su eficacia si se reduce la prescripción desde atención primaria

Tres científicos hablan del regreso de enfermedades, los antibióticos ineficaces y los desastres naturales que marcarán los problemas sanitarios del futuro. De hecho, ya está pasando

Personas sin conocimientos médicos con miles de seguidores en las redes sociales hacen peligrosas recomendaciones sobre el uso de fármacos

La 'Klebsiella pneumoniae' no desarrolló resistencia hasta este siglo, mató a 341 europeos en 2007 y a más de 2.000 en 2015

El Consejo de la profesión en España ultima nuevas guías para hacer frente al aumento de las resistencias

Viñeta de El Roto del 30 de mayo de 2019

La científica alerta de que las resistencias bacterianas provocarán muertes en las edades medias de la vida